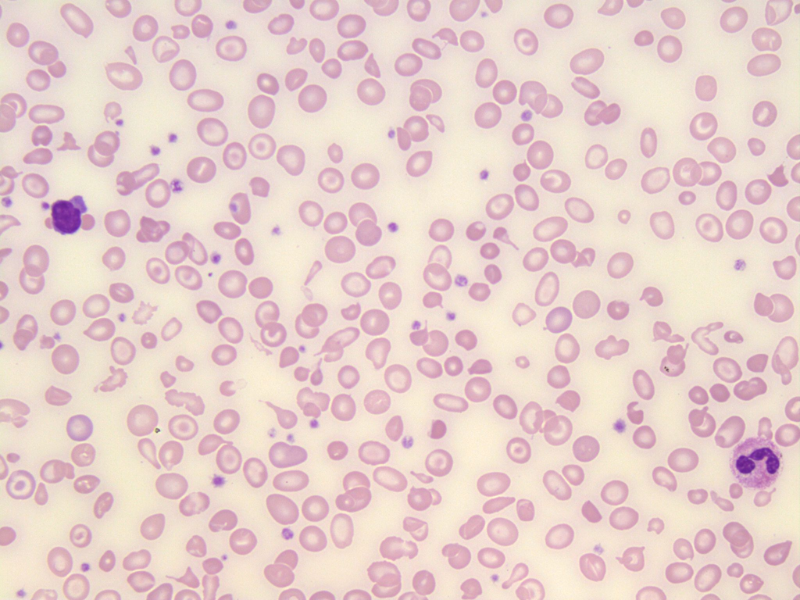

Terungkap Bahaya Thalassemia Mengancam Generasi Indonesia
Thalassemia merupakan penyakit darah bawaan yang hingga kini masih menjadi persoalan besar kesehatan masyarakat di Indonesia. Banyak orang tidak menyadari mereka adalah pembawa sifat (carrier) sehingga berisiko menurunkan penyakit ini pada anak.
Kurangnya skrining pranikah serta rendahnya kesadaran publik membuat jumlah penderita thalassemia mayor terus bertambah setiap tahun dan menambah beban medis maupun sosial keluarga.
Thalassemia: Penyakit Darah Genetik Serius
Thalassemia adalah kelainan darah genetik akibat gangguan pembentukan hemoglobin sehingga sel darah merah mudah rusak dan menyebabkan anemia kronis (Kementerian Kesehatan RI, 2023). Penderita umumnya mengalami keluhan pucat, mudah lelah, sesak napas, hingga gangguan tumbuh kembang pada anak.
Penyakit ini diwariskan jika kedua orang tua sama‑sama membawa gen thalassemia. Anak memiliki peluang hingga 25 persen menderita thalassemia mayor pada setiap kehamilan (Antara News, 2023).
Jenis Thalassemia
Thalassemia terbagi menjadi beberapa tipe utama:
- Thalassemia minor – pembawa sifat tanpa gejala berat.
- Thalassemia intermedia – anemia sedang hingga berat.
- Thalassemia mayor – kondisi paling berat, membutuhkan transfusi darah rutin seumur hidup.
Data Kasus Thalassemia di Indonesia
Ikatan Dokter Anak Indonesia (IDAI) menyebut sekitar 2.500 bayi lahir setiap tahun dengan thalassemia mayor di Indonesia (ANTARA News, 2023).
Pernyataan tersebut sejalan dengan keterangan Kementerian Kesehatan RI yang juga menyebut angka kelahiran bayi bertalasemia sekitar 2.500 kasus per tahun (ANTARA News, 2022).
Media Kompas mencatat thalassemia masih menjadi tantangan serius karena tingginya jumlah carrier di masyarakat yang belum terdeteksi dan masih rendahnya skrining pranikah (Kompas.id, 2022).
Dampak Thalassemia bagi Pasien
Penderita thalassemia mayor umumnya membutuhkan transfusi darah rutin sepanjang hidup untuk mempertahankan kadar hemoglobin agar tetap normal (DetikHealth, 2024).
Beban pengobatan jangka panjang juga disertai risiko komplikasi serius seperti penumpukan zat besi pada organ tubuh. Media Detik melaporkan bahwa kasus talasemia di Indonesia masih terus meningkat, terutama di wilayah dengan kepadatan penduduk tinggi (DetikHealth, 2025).
Pencegahan Thalassemia Lewat Skrining
Pemerintah melalui Kementerian Kesehatan menegaskan bahwa skrining dan deteksi dini merupakan langkah paling penting untuk menekan risiko kelahiran bayi bertalasemia (ANTARA News, 2024).
Program pemeriksaan darah bagi remaja sekolah dan calon pengantin mulai diperluas di berbagai daerah sebagai upaya pencegahan efektif sebelum memasuki jenjang pernikahan.
Thalassemia bukan sekadar penyakit keturunan biasa, tetapi ancaman nyata bagi kualitas hidup generasi Indonesia. Data menunjukkan ratusan hingga ribuan bayi terlahir dengan kondisi berat setiap tahun, yang sebenarnya dapat dicegah melalui skrining dini.
Ikuti berbagai informasi kesehatan terbaru lainnya hanya di Garap Media agar semakin peduli dan waspada terhadap penyakit genetik seperti thalassemia.
Referensi